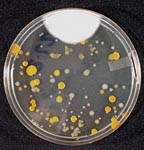

Will the Real Source of Bacteria Please Stand Up?


Microorganisms are by far the most abundant life forms on earth, with a total mass that outweighs that of all plants and animals combined. Microbes are also closely associated with the human body. The human body contains 1013 cells, but it is estimated that there are 10 times as many associated microorganisms.
The diverse metabolic capabilities of microorganisms allow them to survive in an incredible array of environments, including some extreme environments, such as hot springs, boiling water, acidic and basic environments, arctic ice and extremely dry locations. Bacteria exhibit tremendous versatility in their capabilities to utilize a broad range of food materials. Some (lithotrophs) require only water, inorganic (noncarbon-containing) substrates and carbon dioxide for growth. Others (heterotrophs) are capable of breaking down complex, organic, carbon-containing compounds and using them as a source of energy for metabolism.

Given the conditions most optimal for bacteria growth, available nutrients (organic carbon source), moisture, 20 to 40 degrees C temperatures, 5 to 8 pH, and oxygen-containing environments for optimum growth, it is no surprise that electrocoat systems experience bacteria contamination problems.
The increasing cost of bacteria control and the ineffectiveness in some plants of traditional treatments prompted a new look at bacteria and bacteria control. Six Sigma and its methodologies was chosen to tackle this problem. Six Sigma is a problem-solving technology that uses human assets, data, measurements and statistics to identify vital factors that decrease waste and defects while increasing customer satisfaction and profit. Six Sigma consists of five steps: define the problem, measure where you stand, analyze where the problem starts, improve the process and control the new process to confirm that it's fixed.
Define the problem
The increasing number of bacteria infections, the rising cost of bacteria control and the ineffectiveness of traditional treatments are symptoms. The problem was initially defined as bacteria infection in the system. However, the real questions are: Where does the bacteria come from, and how does it get into the electrocoat tank? Once these questions are answered, effective prevention and treatment methods can be developed.The electrocoat tank is exposed to many substances that contain or carry bacteria that could infect the tank. These substances range from the electrocoat feed material and DI water to phosphate rinse drippings off the parts and the electrocoat rinses. Figure 1 illustrates some of the possible sources of bacteria.
These sources would have to be tested for bacteria when the electrocoat tank is infected, and the resulting bacteria would be compared to the bacteria in the electrocoat tank. The bacteria that is related to the bacteria found in the electrocoat tank would most likely be the source. Once the source or sources are identified, treatment and prevention methods can be determined.

Measure where you stand
After converting a number of tanks from older solutions to low-VOC/no-lead coating formulas, some customers experienced an increase in bacteria infections. A comprehensive survey was launched to determine the differences between the plants that were seeing an increase and those that were not. The survey looked at testing, treatment and prevention methods. The survey did not turn up any significant differences between the types of plants. A testing program was developed to test all the possible sources of bacteria when a tank became infected.Regular bacteria testing at plant sites is typically limited to the electrocoat bath, the last DI water rinse in the phosphate area, and the permeate rinses. Bacteria tests are performed using bacteria/fungi (BF) indicators, commonly called dip slides. BF indicators come in a number of different sizes and shapes, all of which operate on the same basic principle and typically use the same nutrient media for microorganism recovery.
One side of the slide has a solid nutrient media ideal for bacteria growth, while the other is formulated to encourage fungal growth. The slide is dipped into the liquid being tested, excess liquid is wicked off, and then the dip slide is incubated at ~30 degrees C for a week. The slide is checked for bacteria growth (usually indicated by red dots) at 48 and 72 h.
Quantitative data is obtained by visually comparing the appearance of the dip slide following incubation with the literature enclosed with the dip slide. Typically, bacteria levels of 10,000 colony-forming units/milliliter (CFU/ml) and higher indicate a strong potential for adverse effects in the electrocoat system and biocide treatment is warranted. Counts of 1,000-10,000 CFU/ml indicate there is a potential for developing a microbial contamination problem, and close inspection is warranted.
Phosphate, permeate and DI water rinse samples may be tested directly using the dip slides, but the electrocoat bath material must be diluted at least 10 times prior to testing. If the bath sample is not diluted, it may dry on the dip slide and inhibit bacteria growth and/or interfere with the ability to see colony growth on the slides.
In this case, the testing program for determining the source of bacteria used sophisticated sampling and testing technologies that determined precisely what level of bacteria is present in each sample. The samples collected from the plants included liquid from the different stages, swabs of the parts and surfaces throughout the system, and scrapings from tank walls. In general, 30 to 50 samples were taken at the targeted plants. The typical locations of the samples taken are illustrated in Table 1.
The samples were checked for bacteria using a plate or dish agar. This type of test will provide a precise bacteria count or level in a sample.
The bacteria from the samples were compared to the bacteria from the electrocoat tank using a RiboPrinter. The RiboPrinter is an automated system developed by Qualicon, a DuPont subsidiary, that identifies and or characterizes bacteria by producing a genetic fingerprint called a RiboPrinter pattern. By comparing the RiboPrinter pattern of bacteria from a specific location with patterns of bacteria from other locations, genetic differences or similarities among the bacteria can be determined. This technology allows the source of bacterial contamination to be definitively tracked because, like fingerprints, no two RiboPrinter patterns are alike. A RiboPrinter pattern is shown in Figure 2.
Analyze
The results from bacteria testing at the infected plants showed that the last DI rinse stages in phosphate were heavily infected, and the electrocoat system contained biofilms. Examples of the bacteria test results are illustrated in Table 2.The results of the RiboPrinter indicated that bacteria in the electrocoat tank are related to the bacteria from the phosphate stages.
Figure 3 shows the RiboPrint patterns of several representative bacterial isolates collected from a customer's electrocoat system. In this example, a total of 18 isolates were subjected to ribotype analysis. Members of nine different ribogroups (isolates with different banding patterns are put into different ribogroups) are shown in Figure 3. Five of these ribogroups had only one member. However, four of the ribogroups had more than one member. For simplicity, these four groups are labeled as E-coat contaminant (ECC)-1, ECC-2, ECC-3 and ECC-4.
Ribogroup ECC-4 consists of five members, including bacteria that were recovered from the E-coat bath and one that was recovered from drippings from a part coming out of the last deionized water rinse before the bath. This suggests the possibility that at least some bacterial contaminants of the main bath are being carried from the last rinse stage of phosphate on parts and transported to the main electrocoat bath. The three members of ECC-1 were found only in the E-coat bath itself. Members of ECC-2 and ECC-3 were found in successive stages in the process, suggesting carryover from previous treatment stages.
Bacteria from the phosphate system were not only infecting the electrocoat bath but initiated a nearly continuous bacterial contamination of the electrocoat bath. This continuous inoculation overwhelmed the biocide and allowed for the development of a biofilm, which made the problem worse by providing another input of bacteria as well as providing additional protection from biocide. A biofilm is a slimy layer consisting of extracellular polysaccharides produced by microorganisms, organics and inorganics that stick to the slimy layer, and microorganisms.
The biofilm serves as a protective matrix with ample nutrients to support microbial growth. Biocides are generally ineffective at penetrating biofilms. Therefore, the biocides kill the bacteria in the liquid, but the biofilm provides a continuous source of new microbial contaminants. This occurs because the outer layers of the biofilm continually slough off into the liquid, causing a continuous microbial assault on the electrocoat system.
This data highlights the need to treat electrocoat bath infections on a system level. Focusing on killing bacteria in the electrocoat bath itself without proper treatment of the other stages will never solve the problem of electrocoat bath contamination.
Improvement and control
The source of the bacteria, biofilms in the electrocoat system and bacteria carried in from the phosphate system has to be eliminated. The bacteria from the phosphate system were also the result of biofilms. The biofilms present in the phosphate and electrocoat systems could only be removed by physically cleaning the systems. The last deionized-water (DIW) stages in phosphate and the electrocoat system were drained and power washed.The systems were filled with DIW, treated with a biocide and allowed to circulate for 24 hours. The systems were drained, rinsed and refilled. The electrocoat tank was treated with biocide. The tank was also analyzed to correct areas of low flow and/or poor circulation. Biofilms will develop first in areas that have low flow.
The last DIW water stages of phosphate are now monitored closely for bacteria. The stages are checked for bacteria weekly. The check consists of a visual inspection and a BF indicator test. If the checks are positive, the stages are treated. The treatments range from adding biocide to dumping and cleaning the systems. Some plants have added UV lights to the last DI stage of phosphate to control bacteria as an extra preventive measure.
The control of bacteria in the last DIW stages of phosphate has prevented bacteria from being carried into the electrocoat system.
Plants with a bacteria problem generally start off treating for bacteria once a month, but they may reduce the interval between treatments to as often as once a week as time goes on. In addition, the plants have to increase the dosage to control the bacteria. The bacteria at some plants would not die, even at higher biocide concentrations.
After the prescribed treatments of the phosphate and electrocoat systems were completed and routine monitoring of the last DIW stages in phosphate was instituted, the electrocoat bath tests negative for bacteria and stays bacteria free.
This is not the end of bacteria problems in electrocoat. Eliminating bacteria from one source will not stop another source from contaminating an electrocoat bath. All sources need to be identified and controlled. There is some cost involved in the procedure, but it is effective.
Bacteria have been around almost since the beginning of time and will probably be around until the end of time.
Looking for a reprint of this article?
From high-res PDFs to custom plaques, order your copy today!





